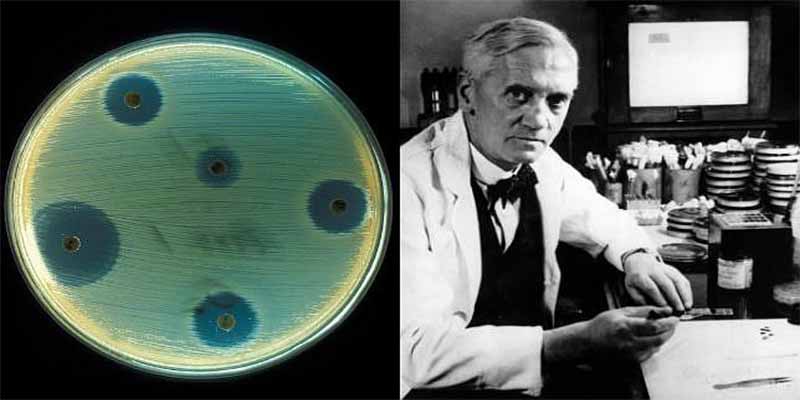

Cuatro investigaciones científicas que parecían absurdas pero brillaron con resultados geniales
Ideas disparatadas como enviar moscas al espacio o bacterias a Marte resultaron en avances clave para la ciencia, demostrando que lo improbable a veces cambia el mundo...
Redirecting to full article...